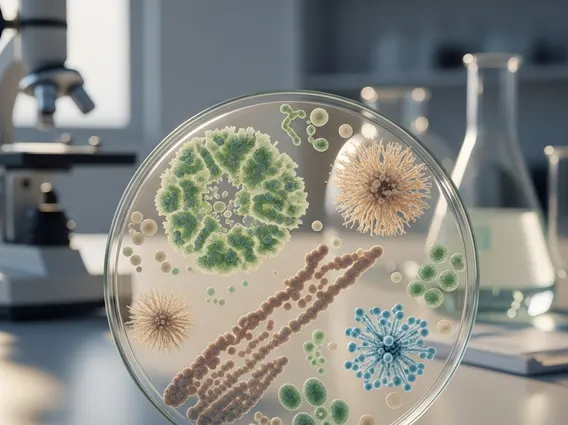
Microflora

Microflora
Microflora, also known as microbiota, refers to the diverse community of microorganisms—including bacteria, fungi, viruses, and archaea—that inhabit various parts of the human body. These microbial communities play a crucial role in maintaining overall health and well-being.
Key Takeaways
- Microflora comprises diverse microorganisms vital for human health, primarily found in the gut.
- It performs essential functions like nutrient metabolism, immune system modulation, and pathogen defense.
- Different types of microflora exist, each with specific roles in various body sites, such as the gut, skin, and oral cavity.
- Maintaining a balanced and diverse microflora through diet and lifestyle is crucial for preventing disease.
What is Microflora and Its Functions?
Microflora refers to the collection of microorganisms, including bacteria, fungi, viruses, and archaea, that naturally reside in and on the human body. While often associated with the gut, these communities are also found on the skin, in the mouth, and in the genitourinary tract. The composition of an individual’s microflora is unique, influenced by genetics, diet, lifestyle, and environmental factors.
The role of microflora in human body is multifaceted and essential for health. These microorganisms contribute significantly to various physiological processes. For instance, in the gut, they aid in the digestion of complex carbohydrates that human enzymes cannot break down, producing short-chain fatty acids (SCFAs) like butyrate, which serve as an energy source for colon cells and have anti-inflammatory properties.
Beyond digestion, the functions of Microflora extend to immune system development and modulation. They help train the immune system to distinguish between harmful pathogens and beneficial microbes, preventing autoimmune responses and allergies. Furthermore, Microflora can synthesize essential vitamins, such as vitamin K and several B vitamins, which are vital for coagulation and metabolic processes. They also form a protective barrier against pathogenic invaders by competing for nutrients and adhesion sites, and by producing antimicrobial substances.
Types of Microflora and Their Importance
The human body hosts various types of Microflora, each adapted to specific environments and performing distinct functions. The most extensively studied is the gut Microflora, primarily located in the large intestine, which can weigh up to 2 kg in an adult. This community is dominated by bacteria from phyla such as Firmicutes and Bacteroidetes.
Other significant microbial communities include:
- Skin Microflora: Composed mainly of bacteria like Staphylococcus, Corynebacterium, and Propionibacterium. It forms a protective barrier against pathogens, helps regulate skin pH, and contributes to immune surveillance.
- Oral Microflora: Found in the mouth, including bacteria like Streptococcus and Lactobacillus. It plays a role in digestion initiation and protects against oral pathogens, though imbalances can lead to dental caries and periodontal disease.
- Vaginal Microflora: Predominantly Lactobacillus species, which produce lactic acid to maintain an acidic environment, inhibiting the growth of harmful bacteria and yeasts.
The importance of these diverse microbial populations lies in their collective contribution to host homeostasis. A balanced and diverse Microflora is associated with better health outcomes, while dysbiosis—an imbalance in microbial composition—has been linked to various conditions, including inflammatory bowel disease, obesity, diabetes, and even neurological disorders. For example, the World Health Organization (WHO) emphasizes the critical role of gut microbiota in preventing and managing non-communicable diseases.
Maintaining Healthy Microflora
Maintaining a healthy and diverse Microflora is crucial for overall well-being. Several lifestyle and dietary strategies can support a balanced microbial community. A diet rich in fiber is paramount, as dietary fibers act as prebiotics, providing nourishment for beneficial gut bacteria.
Key strategies include:
- Consume a Diverse, Plant-Rich Diet: Incorporate a wide variety of fruits, vegetables, whole grains, and legumes. This provides diverse types of fiber and polyphenols that support a broad range of beneficial microbes.
- Include Fermented Foods: Foods like yogurt, kefir, sauerkraut, kimchi, and kombucha contain probiotics—live microorganisms that can confer health benefits when consumed in adequate amounts.
- Limit Processed Foods and Sugars: These can promote the growth of less beneficial bacteria and reduce microbial diversity.
- Avoid Unnecessary Antibiotic Use: Antibiotics can disrupt the delicate balance of Microflora, eradicating beneficial bacteria along with harmful ones. Use them only when medically necessary and as prescribed.
- Manage Stress and Get Adequate Sleep: Chronic stress and sleep deprivation can negatively impact gut Microflora composition and function.
- Regular Physical Activity: Exercise has been shown to positively influence gut microbial diversity and function.
By adopting these practices, individuals can foster a robust and resilient Microflora, enhancing digestive health, bolstering immune function, and potentially reducing the risk of various chronic diseases.